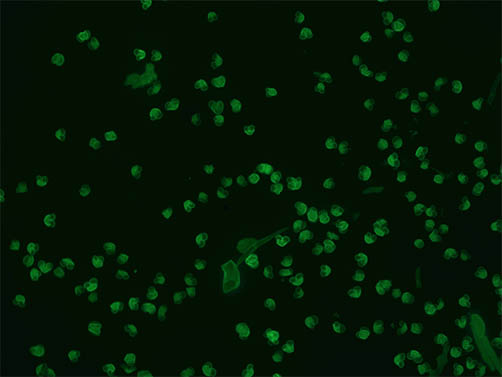

微信扫描二维码,点击右上角 ··· 按钮
转发给朋友或分享到朋友圈
明美倒置荧光显微镜助力丸美集团细胞培养观察
发布时间:2026-02-06
访问量:268
丸美集团老师需要对细胞观察以及转然后的细胞拍照观察,观察培养效果后需要进行拍照保存,对于像素方面和灵敏度都要求需要较好。明美工程师给老师推荐了倒置荧光显微镜MF52-N搭配高像素显微镜相机MSX2.

LED光源的倒置荧光显微镜加上具有高像素高灵敏度的整体方案可以让客户较轻松的获取细胞培养观察以及转然后的细胞拍照观察。

此次推荐的倒置荧光显微镜MF52-N由LED落射荧光显微系统与倒置生物显微系统组成,采用优良的无限远光学系统,配置长工作距离平场物镜与大视野目镜。紧凑稳定的高刚性主体,充分体现了显微操作的防震要求。落射荧光显微系统采用模块化设计理念,可以快捷地调整照明系统,切换荧光滤光片组件。产品可应用于细胞组织,透明液态组织的显微观察,也可用于生物制药,医学检测、疾病预防等领域内的荧光显微观察。
现场由于没有细胞,工程师用倒置荧光显微镜拍摄客户的用植物荧光切片观察,如图:
微信扫描二维码,点击右上角 ··· 按钮
转发给朋友或分享到朋友圈